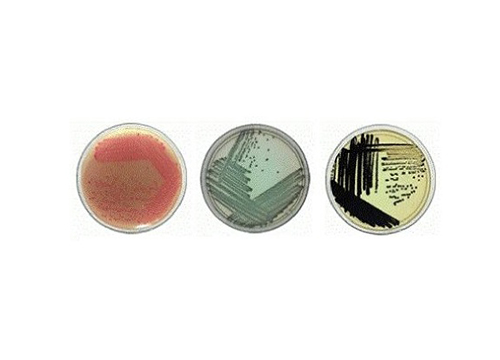

Microbial Detection Using Chromogenic Media
Rainbow Agars offer a simple selective and chromogenic medium to help you conveniently detect strains of E.
coli 0157, Salmonella, Shigella and Aeromonas with results in less than 24 hours
Shigella spp. Application:
Rainbow Agar Shigella/Aeromonas was developed to directly isolate these important causative agents of gastroenteritis. The medium is inhibitory to gram-postive bacteria and most non-enteric gram-negative bacteria, but is not toxic to the target species. Most other enteric species including Escherichia coli are significantly inhibited, and colonies that grow are in blue. Strains of all four Shigella species (sonnei, flexneri, boydii and dysenteriae) as well as some Aeromonas species (hydrophila,jandaei and tructi) grow as the large or medium-sized orange-red colonies.
Salmonella spp. Application:
Rainbow Agar Salmonella utilizes an enhanced detection chemistry to determine H2S production among Salmonella spp., Black colonies are formed by even weak H2S producing strains. In addition, novel ive agents increase the recovery rate of Salmonella while inhibiting the growth of other enteric bacteria and inhibiting H2S production by Citrobacter and other H2S positive enteric species.
E.coli 0157 Application:
Rainbow Agar 0157 has both ive and chromogenic properties that make it particularly useful for isolating pathogenic E. coli strains. The medium contains chromogenic substrates that are specific for two E. coli-associated enzymes: 11-galactosidase (a blue-black chromogenic substrate) and a-glucuronidase (a red chromogenic substrate).